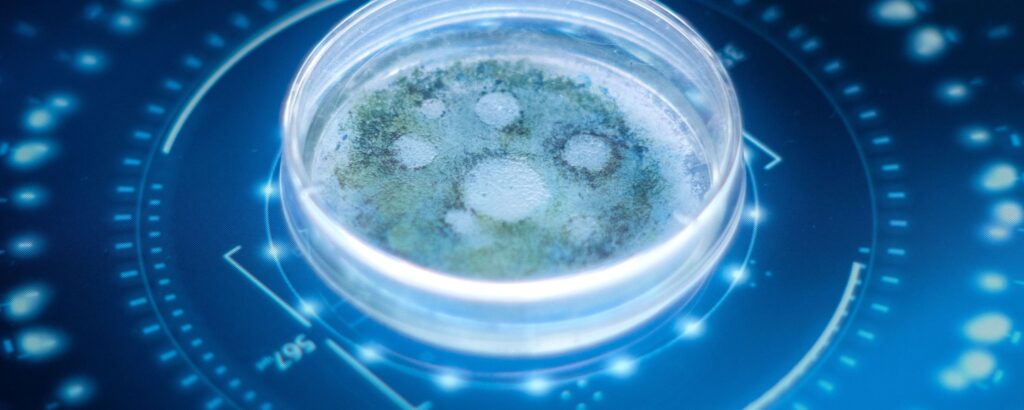

Os maiores avanços tecnológicos de 2025–2026: robôs, chips, 6G e descobertas que estão acontecendo mais rápido do que se imaginava.
Uma nova corrida tecnológica está acontecendo — e quase ninguém percebeu o tamanho dela Se existe uma característica clara nos anos de 2025 e 2026, é a velocidade. Não se trata apenas de novos lançamentos ou melhorias incrementais, mas de uma mudança estrutural no ritmo em que a tecnologia evolui. O que antes levava décadas […]